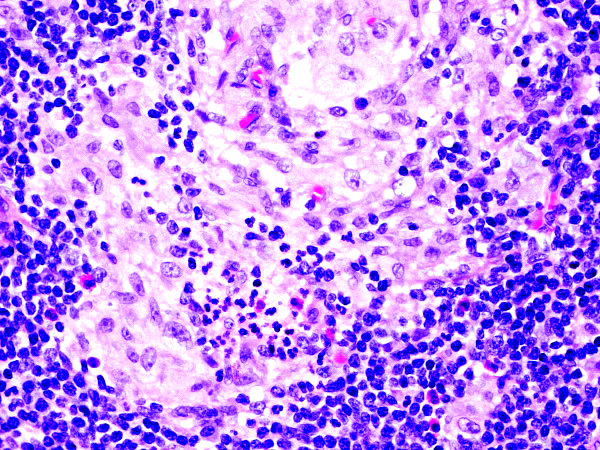

Table of Contents
Actinomyces | Bacillary angiomatosis | bCG | Brucellosis | Coccidioides | Herpes simplex | Histoplasmosis | Leishmania | Leprosy | Lymphogranuloma venereum | Measles | Microfilaria | Mycobacterial spindle cell pseudotumor | Parvovirus B19 | Tuberculosis | Tularemia | Whipple disease | Yersinia pestis | Yersinia pseudotuberculosis | Practice question #1 | Practice answer #1 | Practice question #2 | Practice answer #2Cite this page: DePond WD, Kutty SVM, Pernick N. Other infections. PathologyOutlines.com website. https://www.pathologyoutlines.com/topic/lymphnodesotherinfections.html. Accessed August 1st, 2025.
Actinomyces
Definition / general
- Rare
- Associated with poor dental hygiene (is a normal inhabitant of the oral cavity)
- Causes lymphadenopathy
Gram stain
- Gram positive, filamentous branching bacteria
Treatment
- Appropriate dental care and antibiotics
Case reports
- 12 year old girl with retroperitoneal tumor with rib involvement (Eur J Pediatr Surg 2005;15:38)
Gross description
- Tan-white cut surface, multiple pinpoint white spots
Microscopic (histologic) description
- Marked capsular fibrotic thickening with thick fibrous bands dividing nodes into nodules
- Also follicular hyperplasia, marked interfollicular fibrosis and multiple interfollicular microabscesses containing focal Actinomyces colonies with classic sulfur granules (may require deeper levels to identify)
- No palisading of histiocytes around the abscesses
- Numerous macrophages are present in germinal centers
Cytology images
Images hosted on other servers:
Differential diagnosis
- Cat-scratch disease
- Lymphogranuloma venereum:
- Palisading histiocytes present
- Syphilis:
- Fibrotic capsule but also prominent plasma cells
Additional references
Bacillary angiomatosis
Definition / general
- Caused by Bartonella (formerly Rochalimaea) henselae, which also causes cat-scratch disease
- May also be caused by Bartonella quintana (Ann N Y Acad Sci 2005;1063:302)
- Almost all patients are HIV+ or otherwise immunosuppressed
- May have multiple red / violet skin lesions resembling Kaposi sarcoma but also involves lymph nodes and spleen
- Bacterial reservoir is domestic cats (transmit to humans) and cat fleas (transmit to other cats)
- May appear neoplastic but is reactive
Gram stain
- Small, curved, motile, gram negative rod that is difficult to culture
Diagnosis
- PCR
Case reports
- 17 year old renal transplant patient with persistent fever, pancytopenia and axillary lymphadenopathy (Arch Pathol Lab Med 2004;128:e12)
Treatment
- Erythromycin, other macrolides or doxycycline are very effective
Microscopic (histologic) description
- Focal nodal effacement by multiple coalescing intranodal clusters of small blood vessels, lined by epithelioid endothelial cells with pale cytoplasm
- May have focal nuclear atypia
- Interstitium contains abundant eosinophilic to amphophilic, amorphous or granular material containing aggregates of bacteria (highlighted by Warthin-Starry stain)
- Also neutrophils
Microscopic (histologic) images
AFIP images
Differential diagnosis
- Epithelioid hemangioma or hemangioendothelioma:
- Eosinophilic and vacuolated cytoplasm
- No amorphous / granular material
- Kaposi sarcoma:
- Cleft-like vessels, spindled endothelial cells, no bacteria
Additional references
bCG
Definition / general
- Post vaccination bacille Calmette-Guerin infection occurs in 1% of infants, although swelling usually subsides (Braz J Med Biol Res 2004;37:697)BACILLARY ANGIOMATOSIS Left: Proliferated blood vessels are separated by abundant eosinophilic, vaguely fibrillary material. Some neutrophils are also seen. Right: Barely canalized blood vessels separated by eosinophilic interstitial materials in the absence of neutrophils.
- Patients with normal immunity have complete recovery after postvaccination bCG infection after excision of infected lymph node; immunosuppressed patients may require antiTB therapy to avoid fatal disseminated infection (Am J Clin Pathol 2000;113:703)
Case reports
- 3 month old Chinese baby with post bcg vaccination lymphadenitis (Arch Dis Child 2004;89:812)
- 68 year old man with cervical lymphadenitis post-bCG for bladder cancer (Respiration 2001;68:420)
Treatment
- Surgery for large (3 cm) nodes, anti-TB therapy for small (1 cm) nodes (J Ayub Med Coll Abbottabad 2005;17:16)
Microscopic (histologic) description
- Patients with normal immunity:
- Multiple epithelioid granulomas and Langhans giant cells
- Variable suppuration, minimal caseous necrosis
- Few acid fast bacteria identified with Ziehl-Neelsen stain
- Immunosuppressed patients:
- Histiocytes with abundant gray cytoplasm containing numerous acid fast bacilli, plump nuclei
Cytology description
- Poorly to moderately cellular smears of epithelioid histiocytes in a granuloma pattern with occasional multinucleated Langerhans type giant cells, lymphocytes and neutrophils
- Background is finely granular with necrotic debris
- Isolated calcified spherules (Diagn Cytopathol 2001;25:134)
- May be heavy involvement of acid fast bacilli (World J Surg Oncol 2003;1:25)
Additional references
Brucellosis
Definition / general
- Due to Brucella abortus, melitensis or suis
- Either occupational or food related (milk and cheese)
- Fever, hepatosplenomegaly, rarely lymphadenopathy
Case reports
- 22 year old woman with Kikuchi-Fujimoto necrotizing lymphadenitis associated with brucellosis (Sangre (Barc) 1992;37:201)
- 43 year old man with B. melitensis and subsequent Kikuchi-Fujimoto disease (In Vivo 2003;17:51)
Diagnosis
- Culture, PCR, serology
Microscopic (histologic) description
- Follicular hyperplasia, clusters of epithelioid histiocytes that may form large noncaseating granulomas
- Eosinophils, plasma cells, immunoblasts
Differential diagnosis
Coccidioides
Definition / general
- Also called San Jaquin Valley Fever
- Dimorphic fungus with distinct yeast and mold stages
- Endemic to Lower Sonoran Desert (southwest US, Central and South America)
- Usually self limiting but more severe disease in immunocompromised hosts
Case reports
- 27 year old man on steroids for clinical pneumonia with enlarged paratracheal lymph node (Arch Pathol Lab Med 2005;129:699)
Diagnosis
- Culture (grows on all media)
- Has enteroarthric conidia (alternating segments of hyphae undergo autolysis, while surviving segments form infective barrel shaped multinucleate arthroconidia)
Microscopic (histologic) description
- Thick walled spherules 20 - 150 microns containing 3 - 5 micron endospores, surrounded by a giant cell granulomatous reaction
Additional references
Herpes simplex
Definition / general
- HSV lymphadenitis is very uncommon
- Usually inguinal nodes (Am J Clin Pathol 1991;95:709)
- Often associated with hematopoietic malignancies
Case reports
- 23 year old woman with lymphadenitis before appearance of cutaneous vulvar lesions (Arch Pathol Lab Med 1985;109:1043)
- 43 year old man with immunodeficiency (Clin Infect Dis 2002;34:1)
- 43 year old woman with mantle cell lymphoma (Arch Pathol Lab Med 2006;130:536)
- 59 year old man with HSV infection resembling Richter transformation (Am J Hematol 2001;68:287)
Microscopic (histologic) description
- Well circumscribed necrosis, follicular and paracortical hyperplasia (Histopathology 1991;19:355)
- Cells have intranuclear inclusions, particularly at edge of necrotic areas
- Also marked immunoblasts, T cell hyperplasia
Microscopic (histologic) images
Contributed by Mark R. Wick, M.D.
Positive stains
- HSV
Electron microscopy description
- Intranuclear and cytoplasmic virus particles (Am J Surg Pathol 1990;14:571)
Histoplasmosis
Definition / general
- May clinically mimic tuberculosis
Microscopic (histologic) description
- Chronic suppurative lesion
- Granulomatous process or widespread nodal necrosis with diffuse sinus histiocytosis (Centers for Disease Control and Prevention: Histoplasmosis [Accessed 3 July 2018])
Microscopic (histologic) images
Contributed by Mark R. Wick, M.D.
Positive stains
Leishmania
Definition / general
- Parasites may continue in lymph nodes after clinical cure (J Infect 2003;47:77)
Case reports
- 8 year old boy with atypical presentation with hepatitis and adenopathy in disseminated disease (Trans R Soc Trop Med Hyg 2006;100:79)
Microscopic (histologic) description
- Granulomas with abundant plasma cells, focal fibrosis, variable necrosis, leishmanian amastigotes (by immunostain, Am J Clin Pathol 1994;102:11)
Cytology description
- Polymorphous lymphocytes, histiocytes, plasma cells, giant cells and tingible body macrophages
- Amastigote forms within histiocytes and multinucleated giant cells and extracellularly (Acta Cytol 2005;49:286)
Leprosy
Diagnosis
- PCR, immunofluorescence
Case reports
- 25 year old man with coexisting tuberculosis (Lepr Rev 1999;70:345)
Microscopic (histologic) description
- Lepromatous leprosy exhibits large, pale, round histiocytes without granulomas and with no / rare necrosis
Microscopic (histologic) images
Images hosted on other servers:
Positive stains
- Acid fast (modified Ziehl-Neelsen)
Differential diagnosis
- Lymphoma:
- Clinically (Lepr Rev 2005;76:87)
Lymphogranuloma venereum
Definition / general
- Sexually transmitted disease caused by Chlamydia trachomatis serotypes L1, L2 and L3 (Mod Pathol 1995;8:924, MedlinePlus: Lymphogranuloma venereum [Accessed 3 July 2018], eMedicine: Lymphogranuloma Venereum (LGV) in Emergency Medicine [Accessed 3 July 2018], Wikipedia: Lymphogranuloma venereum [Accessed 3 July 2018])
- Endemic in tropical areas, rare in industrialized countries
- Outbreaks in Western Europe
- Among male homosexuals (Rev Prat 2005;55:1747)
- In Bahamas associated with crack cocaine and HIV (Sex Transm Dis 2002;29:253)
- Three clinical stages
Diagnosis
- PCR
- Previously Frei test (delayed hypersensitivity skin test using "lygranum" chlamydial antigen)
Treatment
- Doxycycline for 21 days
Microscopic (histologic) description
- Early: tiny necrotic foci with neutrophils
- Late: stellate abscesses surrounded by pale epithelioid cells
- Abscesses may merge and sinus tracts may develop
- Macrophages may have organisms within vacuoles
Microscopic (histologic) images
Contributed by Mark R. Wick, M.D.
Electron microscopy description
- Elementary and reticulate bodies
Differential diagnosis
Measles
Definition / general
- Live attenuated vaccine may cause regional lymphadenopathy
- Measles associated lymphopenia may be due to apoptosis of uninfected lymphocytes (Arch Virol 2000;145:905)
- Fatal measles cases in South African in 1976-1982 were associated with malnutrition; caused depletion of T cell zones (S Afr Med J 1985;68:858)
Case reports
- 14 month old boy with familial immunodeficiency and necrotizing lymphadenitis with Warthin-Finkeldey type giant cells after measles vaccination (Ultrastruct Pathol 1980;1:243)
Microscopic (histologic) description
- Polykaryocytes
- In germinal centers, Warthin-Finkeldey giant cells have large nuclei and B cell markers
- In interfollicular areas they have small hyperchromatic nuclei and T cell markers (Pathol Int 1994;44:442)
Microscopic (histologic) images
Images hosted on other servers:
Microfilaria
See also related Breast topic
Definition / general
Essential features
Epidemiology
Pathophysiology
Clinical features
Diagnosis
Treatment
Microscopic (histologic) description
Microscopic (histologic) images
Contributed by Sajna V.M. Kutty, M.D.
Board review style question
Definition / general
- Filariasis is due to infection by threadlike nematodes of the family Filarioidea
- Filarial infection can cause lymphedema of the limbs (elephantiasis), genital disease (hydrocele, chylocele and swelling of the scrotum and penis) and recurrent painful acute attacks (WHO: Lymphatic filariasis [Accessed 29 March 2021])
Essential features
- Wuchereria bancrofti accounts for up to 90% of cases
- Diagnosis is typically made by identifying microfilariae in peripheral blood smears
- Rarely, microfilariae are coincidentally detected in FNAC in association with various inflammatory and neoplastic lesions
- Wuchereria bancrofti can be identified by its sheath and multiple, coarse, discrete nuclei extending from head to tail except in the small terminal portion of the caudal end
Epidemiology
- Major public health problem in India, China, Indonesia, Africa and the Far East
Pathophysiology
- Wuchereria bancrofti accounts for up to 90% of cases
- Adult worms lodge in the lymphatics, where females release larvae (microfilaria) which periodically circulate in the blood and are occasionally ingested by feeding mosquitoes
- Microfilaria mature in the mosquitoes before becoming infective and are spread to new humans during mosquito feeding
Clinical features
- Humans are the exclusive host of infection with W. bancrofti
- Many infected individuals remain asymptomatic and serve as potential sources of infection
- Virtually all infected people have subclinical lymphatic damage and up to 40% have kidney damage with proteinuria and hematuria
Diagnosis
- Diagnosis is typically made by identifying microfilariae in peripheral blood smears
- Rarely, microfilariae are coincidentally detected in FNAC in association with various inflammatory and neoplastic lesions (J Cytol 2010;27:78, J Cytol 2017;34:43)
- Finding microfilaria in cytosmears is rare
Treatment
- Treatment consists of multiple doses of albendazole and ivermectin to the entire at risk population, in addition to mosquito control
Microscopic (histologic) description
- Wuchereria bancrofti can be identified by its sheath and multiple, coarse, discrete nuclei extending from head to tail except in the small terminal portion of the caudal end
Microscopic (histologic) images
Contributed by Sajna V.M. Kutty, M.D.
Board review style question
Mycobacterial spindle cell pseudotumor
Definition / general
- HIV+ patients, often involvement of many sites
- Also infants after
- bCG vaccination (Zhonghua Bing Li Xue Za Zhi 2001;30:89)
- Posttransplant (Am J Clin Pathol 1985;83:524)
- Spindle cells are macrophages with large amounts of mycobacteria (Am J Surg Pathol 1992;16:276)
- Intraoperative touch imprints may demonstrate numerous intracellular organisms (Arch Pathol Lab Med 1995;119:811)
Radiology images
Contributed by Chunyu Cai, M.D., Ph.D. (Case #532)
Case reports
- 35 year old HIV+ man with diffuse lymphadenopathy (Case of the Week #218)
- 52 year old man with a history of HIV infection and Kaposi sarcoma 5 years prior, presented with lower extremity weakness (Case of the month #532)
Treatment
- Antiretroviral therapy for HIV
- Antibiotics
Microscopic (histologic) description
- Nodes show partial / complete effacement by storiform pattern of bland spindle cells, some with vacuoles
- Numerous vessels lined by plump endothelial cells, plasma cells and lymphocytes
- No multinucleated tumor cells, no foamy histiocytes
Microscopic (histologic) images
Contributed by AFIP and Chunyu Cai, M.D., Ph.D. (Case #532)
Cytology description
- Spindle cell proliferation resembling Kaposi sarcoma; no foamy histiocytes (Acta Cytol 1995;39:125)
Positive stains
Differential diagnosis
- Kaposi sarcoma:
- Fascicular spindle cells, slit-like spaces, mitotic figures, no granular or acidophilic cytoplasm
- Spindle cells are CD31+ and CD34+
- S100- and CD68- (Am J Surg Pathol 1999;23:656)
- Smooth muscle tumor
Board review style question
Parvovirus B19
Definition / general
- In adults, parvovirus B19 infection is associated with fever (81%), arthralgia / myalgia (62%), skin rash (48%), general fatigue (43%), lymphadenopathy (38%) and edema (38%) (Intern Med 2002;41:295)
- May be associated with hemophagocytic syndrome (Br J Haematol 1997;96:868)
Diagnosis
- PCR
- Immunohistochemistry
Case reports
- 16 year old girl with cervical lymphadenopathy, fever and fatigue (J Clin Pathol 2005;58:872)
Microscopic (histologic) description
- Massive nodular histiocytic proliferation resembling Kikuchi disease with prominent apoptosis but no necrosis
- One case showed florid reactive hyperplasia with paracortical expansion, neutrophils and hemophagocytosis (Pathol Int 1998;48:829)
Microscopic (histologic) images
Images hosted on other servers:
Tuberculosis
See also: Lung - nontumor chapter
Definition / general
Diagnosis
Case reports
Gross description
Gross images
Contributed by Mark R. Wick, M.D.
Images hosted on other servers:
Microscopic (histologic) description
Microscopic (histologic) images
Contributed by Mark R. Wick, M.D.
Images hosted on other servers:
Definition / general
- Usually nodal involvement of cervical region (scrofula), often with draining sinus to skin
- Generalized TB in AIDS cases at autopsy show thoracic or abdominal nodal involvement in almost all cases, although TB often not diagnosed prior to death (Arch Pathol Lab Med 2000;124:1267)
- Needle biopsy of enlarged nodes may be helpful in smear negative, HIV+ patients with suspected TB (Int J Tuberc Lung Dis 2005;9:220)
Diagnosis
- PCR (preferred, J Clin Pathol 2000;53:355)
- Ligase chain reaction (Scand J Infect Dis 2004;36:724)
- Immunostains
- Culture
Case reports
- 8 year old boy with chronic renal failure and mediastinal nodal TB (Clin Exp Nephrol 2006;10:152)
- 52 year old woman with TB and metastatic breast carcinoma in axillary node (World J Surg Oncol 2003;1:3)
- 63 year old woman with Hodgkin lymphoma (Med Klin (Munich) 2006;101:500)
- 82 year old woman with coinfection with Trichomonad tenax (Hum Pathol 2000;31:1317)
Gross description
- Large multinodular mass that resembles carcinoma with multiple foci of caseous necrosis
Gross images
Contributed by Mark R. Wick, M.D.
Images hosted on other servers:
Microscopic (histologic) description
- Either multiple small epithelioid granulomas or huge epithelioid granulomas with prominent Langhans giant cells and central necrosis (J Clin Pathol 1988;41:93)
Microscopic (histologic) images
Contributed by Mark R. Wick, M.D.
Images hosted on other servers:
Tularemia
Definition / general
- Caused by Francisella tularensis, a gram negative coccobacilli found in rodents, rabbits and hares, transmitted by ticks and deer flies
- Commonly due to food and water contamination by rodents, hunting hares and mosquito bites (Med Clin (Barc) 2002;119:455, Emerg Infect Dis 2002;8:956)
- Also a virulent, potential biowarfare agent (Centers for Disease Control and Prevention: Tularemia [Accessed 2 July 2018], eMedicine: Tularemia [Accessed 2 July 2018])
- Symptoms: sudden fever, chills, headaches, diarrhea, muscle aches, joint pain, dry cough, progressive weakness; also pneumonia, skin / mouth ulcers, lymphadenopathy, eye involvement
- Ulceroglandular form: prominent lymphadenopathy of either axilla (mammalian vectors, such as handling rabbits) or cervical / inguinal regions (arthropod vectors)
Diagnosis
- Rise in titers
- PCR (Mod Pathol 2004;17:489)
- Immunofluorescence (Scand J Infect Dis 2004;36:785)
Microscopic (histologic) description
- Early: reactive changes
- Second week: abscess with variable epithelioid cell reaction
- Fourth week: caseous necrosis, diffuse lymphadenitis
- Late: granulomatous reactions that may resemble TB
- Often extracapsular inflammation (Arch Pathol Lab Med 1986;110:42)
Differential diagnosis
Whipple disease
Definition / general
- Rare; due to infection by Tropheryma whipplei, present in soil and sewage but not animals
- Typically affects farmers and outdoor workers
- Symptoms include diarrhea, malabsorption, weight loss, fever, arthralgias; also occasional CNS and cardiac involvement
- May cause marked enlargement of mesenteric and periaortic lymph nodes; enlargement of peripheral lymph nodes may occur early
- Diagnosis requires massive involvement of node plus intense PAS+ staining (small aggregates of PAS+ macrophages are nonspecific) or PCR
- Gram stain: gram+ bacteria
Case reports
- 55 year old woman with mesenteric lymphadenopathy and a monoclonal B cell proliferation (Arch Pathol Lab Med 2003;127:1619)
Treatment
- IV penicillin and streptomycin or third generalization cephalosporin for 10 - 14 days, plus cotrimoxazone for 1 year
Microscopic (histologic) description
- Nodal architecture obscured by ill defined lipogranulomas
- Involvement of sinuses by macrophages with foamy cytoplasm
Microscopic (histologic) images
Contributed by Mark R. Wick, M.D.
Positive stains
- PAS+ diastase resistant bacilli within histiocytes
- Immunostains for bacteria (Am J Clin Pathol 2002;118:742)
Negative stains
Electron microscopy description
- Rod-like organisms
Electron microscopy images
Images hosted on other servers:
Molecular / cytogenetics description
- PCR to confirm diagnosis; difficult to culture (Am J Clin Pathol 2001;116:898)
Differential diagnosis
Yersinia pestis
Definition / general
- Similar to Y. pseudotuberculosis
Clinical features
- Infection is usually limited to lymph nodes ("bubo" as in bubonic plague) and is self limited
- Clinical picture may resemble acute appendicitis but laparotomy often shows mesenteric lymphadenitis (Pediatr Surg Int 1998;13:2)
- Pneumonic plague occurs if bacterial are aerosolized (eMedicine: Plague [Accessed 2 July 2018], Wikipedia: Bubonic Plague [Accessed 2 July 2018])
Diagnosis
- Gram stain: gram negative, polymorphic, coccoid or ovoid mobile bacteria
- PCR
- Cultures
Case reports
- 46 year old woman with weight loss and abdominal lymphadenopathy (Radiologe 1998;38:37)
Microscopic (histologic) description
- Capsular thickening and edema
- Immunoblasts and plasma cells in cortical and paracortical region
- Large lymphocytes within sinuses, germinal center hyperplasia
- No granulomas (unlike Y. pseudotuberculosis)
- Depletion of lymphocytes, edema, necrosis, foamy macrophages
- Bacteria may involve blood vessels
Positive stains
- Yersinia immunostain (Am J Clin Pathol 2002;117:205)
Yersinia pseudotuberculosis
Definition / general
- Clinical picture usually resembles acute appendicitis with possible abdominal mass but laparotomy often shows mesenteric lymphadenitis (Eur J Pediatr Surg 1997;7:180)
- Usually self limited but may be associated with Kawasaki disease (Kansenshogaku Zasshi 2005;79:895, Acta Paediatr 1997;86:661)
- Ampicillin reduces fetal excretion of bacteria but provides no clinical benefit (Pediatr Infect Dis J 1988;7:686)
- Gram stain: gram negative, polymorphic, coccoid or ovoid mobile bacteria
Diagnosis
- PCR
- Cultures
Gross description
- Inflammation of terminal ileum and cecum
Microscopic (histologic) description
- Capsular thickening and edema
- Granulomas with central necrosis and microabscesses
- Immunoblasts and plasma cells in cortical and paracortical region, large lymphocytes within sinuses, germinal center hyperplasia
Additional references
Practice question #1
Practice answer #1
Practice question #2
A 52 year old AIDS patient with low CD4 count presented with multiple enhancing brain nodules. Infectious workup revealed disseminated mycobacterium avium intracellulare complex. Biopsy of the brain nodule showed a tumor with mixed spindle and epithelioid cells. What is the mostly likely immunohistochemical profile of this tumor?
- CD31+, CD68-, SMA-,EBER-, HHV8+
- CD31-, CD68+, SMA-, EBER-, HHV8-
- CD31-, CD68-, SMA+, EBER+, HHV8-
- CD31-, CD68-, S100+, EBER-, HHV8-
Practice answer #2
B. CD31-, CD68+, SMA-, EBER-, HHV8-. This describes mycobacteria pseudotumor. Answer A is incorrect because it describes Kaposi sarcoma. Answer C is incorrect because it describes leiomyosarcoma. Answer D is incorrect because it describes schwannoma. See Case #532 for more information.
Comment Here
Reference: Other infections
Comment Here
Reference: Other infections